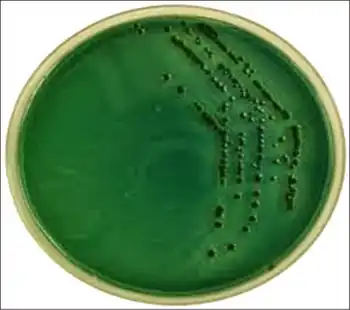

Vibrio parahaemolyticus infection
| Vibrio parahaemolyticus infection | |
|---|---|
| Other names: Vibrio infection[1] | |
![]() | |
| Positive Vibrio parahaemolyticus culture | |
| Specialty | Infectious disease |
| Symptoms | Abdominal cramps, nausea, vomiting, fever[2] |
| Complications | Dehydration, sepsis[2] |
| Causes | Vibrio parahaemolyticus[2] |
| Risk factors | Weak immune system[2] |
| Diagnostic method | Isolated from cultures stool, wound, or blood[2] |
| Differential diagnosis | Cholera, bacterial gastroenteritis[2] |
| Prevention | Avoid eating raw/undercooked seafood[2] |
| Treatment | Rehydration, antibiotics[2] |
Vibrio parahaemolyticus infection (V. parahaemolyticus) is due to a curved, rod-shaped, Gram-negative bacterium found in the sea and in estuaries which, when ingested, may cause gastrointestinal illness in humans. [3][2]
Treatment may be supportive as most cases are self-limiting; however in more severe cases hydration and antibiotics may be needed[2]
Signs and symptoms
There is an incubation period of about 24 hours is followed by intense watery or bloody diarrhea accompanied by nausea, vomiting, abdominal cramps, and sometimes a fever. Symptoms typically resolve within 72 hours, but can persist for up to 10 days in immunocompromised individuals.[3][2][4]
Skin infections can occur also, these arise when an open wound comes into contact with contaminated seawater, leading to redness, swelling, or pain around the wound.[5]
-
Fever -
a-c)Wound and blister formation on left lower limb, from inner ankle to the entire dorsum of foot[5]
Complications
Among the possible complications an individual with Vibrio parahaemolyticus infection may have are:[2]
- DIC
- Reactive arthritis
- Multiorgan failure
Cause
| Vibrio parahaemolyticus infection | |
|---|---|
| |
| SEM image of V. parahaemolyticus | |
| Scientific classification | |
| Domain: | Bacteria |
| Kingdom: | Pseudomonadati |
| Phylum: | Pseudomonadota |
| Class: | Gammaproteobacteria |
| Order: | Vibrionales |
| Family: | Vibrionaceae |
| Genus: | Vibrio |
| Species: | V. parahaemolyticus
|
| Binomial name | |
| Vibrio parahaemolyticus (Fujino et al. 1951)
Sakazaki et al. 1963 | |
The bacteria which causes the infection is V. parahaemolyticus it is rod-shaped or curved and Gram-negative, 0.5 to 1 µm diameter[6]V. parahaemolyticus is oxidase positive, facultatively aerobic, and does not form spores. Like other members of the genus Vibrio, this species is motile, with a single, polar flagellum.[3]
Hosts
Hosts of V. parahaemolyticus include:
Pathogenesis

While infection can occur by the fecal-oral route, ingestion of bacteria in raw or undercooked seafood, usually oysters, is the predominant cause of the acute gastroenteritis caused by V. parahaemolyticus.[12] Wound infections also occur, but are less common than seafood-borne disease. The disease mechanism of V. parahaemolyticus infections has not been fully elucidated.[13]
Clinical isolates usually possess a pathogenicity island (PAI) on the second chromosome. The PAI can be acquired by horizontal gene transfer and contains genes for several virulence factors. Two fully sequenced variants exist of the V. parahaemolyticus PAI with distinctly different lineages.[14][15] Each PAI variant contains a genetically distinct Type III Secretion System (T3SS), which is capable of injecting virulence proteins into host cells to disrupt host cell functions or cause cell death by apoptosis. The two known T3SS variants on V. parahaemolyticus chromosome 2 are known as T3SS2α and T3SS2β. These variants correspond to the two known PAI variants. Aside from the T3SS, two genes encoding well-characterized virulence proteins are typically found on the PAI, the thermostable direct hemolysin gene (tdh) and/or the tdh-related hemolysin gene (trh). Strains possessing one or both of these hemolysins exhibit beta-hemolysis on blood agar plates. A distinct correlation seems to exist between presence of tdh, trh, and the two known T3SS variants: observations have shown T3SS2α correlating with tdh+/trh- strains, while T3SS2β correlates with tdh-/trh+ strains.[16]
Diagnosis
As to the evaluation of Vibrio parahaemolyticus infection the following can be done:[2]
- Stool sample
- Blood culture
- Wound cultures
Differential diagnosis

In terms of the differential diagnosis we find the following:[2]
Treatment
In terms of management we find that it is supportive;include intravenous fluid rehydration. However in severe case of gastroenteritis, doxycycline should be used. [2]
In wound infections, minocycline or doxycycline may be used[2]
Epidemiology
Outbreaks tend to be concentrated along coastal regions during the summer and early fall when higher water temperatures favor higher levels of bacteria. Seafood most often implicated includes squid, mackerel, tuna, and bivalves, such as oysters and clams. In the Northeast United States, there is an increasing incidence of illness due to oysters contaminated with V. parahaemolyticus, which is associated with warmer waters from the Gulf of Mexico moving northward.[17][18]
Additionally, swimming or working in affected areas can lead to infections of the eyes, ears,[19] or open cuts and wounds.
Following Hurricane Katrina, 22 wounds were infected with Vibrio, three of which were caused by V. parahaemolyticus, and two of these led to death.[20][21]
-
Vibrio parahaemolyticus outbreaks, Zhejiang, China 2010–2022[22] -
V. parahaemolyticus epidemiology around the world[17]
History
Vibrio parahaemolyticus was first discovered by Tsunesaburo Fujino in 1950. He identified it as the causative agent of a large foodborne disease outbreak in Japan, which resulted in 272 illnesses and 20 deaths after the consumption of shirasu (sardines)[23]
References
- ↑ "About Vibrio Infection". Vibrio Infection (Vibriosis). 16 May 2024. Archived from the original on 1 March 2025. Retrieved 5 March 2025.
- ↑ 2.00 2.01 2.02 2.03 2.04 2.05 2.06 2.07 2.08 2.09 2.10 2.11 2.12 2.13 2.14 2.15 Rezny, Benjamin R.; Evans, Daniel S. (2025). "Vibrio parahaemolyticus Infection". StatPearls. StatPearls Publishing. PMID 29083695. Archived from the original on 2025-02-02. Retrieved 2025-02-23.
- ↑ 3.0 3.1 3.2 Ryan KJ, Ray CG, eds. (2004). Sherris Medical Microbiology (4th ed.). McGraw Hill. ISBN 0-8385-8529-9.
- ↑ "Vibrio parahaemolyticus | Texas DSHS". www.dshs.texas.gov. Retrieved 24 March 2025.
- ↑ 5.0 5.1 Xu, Weixian; Chen, Miaozhen; Chen, Xinxi; Su, Yi; Tang, Liqun; Zhang, Yunhai (15 January 2024). "Vibrio parahaemolyticus infection caused by market sewage: A case report and literature review". Heliyon. 10 (1). doi:10.1016/j.heliyon.2023.e23461. ISSN 2405-8440.
{{cite journal}}: CS1 maint: unflagged free DOI (link) - ↑ "V . parahaemolyticus" (PDF). ANSES. Archived (PDF) from the original on 8 November 2022. Retrieved 23 February 2025.
- ↑ 7.0 7.1 Kumazawa, NH; Kato, E; Takaba, T; Yokota, T (1988). "Survival of Vibrio parahaemolyticus in two gastropod molluscs, Clithon retropictus and Nerita albicilla". Nihon Juigaku Zasshi. The Japanese Journal of Veterinary Science. 50 (4): 918–24. doi:10.1292/jvms1939.50.918. PMID 3172602.
- ↑ Zakaria, Nor Hafizah; Abd Rahim, Noorul Darlina Edlin; Rosilan, Nur Fathiah; Sung, Yeong Yik; Waiho, Khor; Harun, Sarahani; Zainal Abidin, Rabiatul Adawiah; Afiqah-Aleng, Nor (23 January 2025). "Global landscape of Vibrio parahaemolyticus research: a bibliometric analysis". World Journal of Microbiology and Biotechnology. 41 (2): 45. doi:10.1007/s11274-025-04262-5. ISSN 1573-0972. PMID 39843643.
- ↑ "Vibrio parahaemolyticus and raw Pacific oysters from Coffin Bay, SA". Food Standards Australia New Zealand (FSANZ). Archived from the original on 2021-12-04. Retrieved 2021-12-04.
- ↑ "Coffin Bay Oysters Recalled". Government of South Australia. Archived from the original on 2021-12-04. Retrieved 2021-12-04.
- ↑ Letchumanan, V; Chan, KG; Khan, TM; Bukhari, SI; Ab Mutalib, NS; Goh, BH; Lee, LH (2017). "Bile Sensing: The Activation of Vibrio parahaemolyticus Virulence". Frontiers in Microbiology. 8: 728. doi:10.3389/fmicb.2017.00728. PMC 5399080. PMID 28484445.
- ↑ Finkelstein RA (1996). Baron S; et al. (eds.). Cholera, Vibrio cholerae O1 and O139, and Other Pathogenic Vibrios. In: Barron's Medical Microbiology (4th ed.). Univ of Texas Medical Branch. ISBN 0-9631172-1-1. (via NCBI Bookshelf).
- ↑ Baffone W, Casaroli A, Campana R, et al. (2005). "'In vivo' studies on the pathophysiological mechanism of Vibrio parahaemolyticus TDH(+)-induced secretion". Microb Pathog. 38 (2–3): 133–7. doi:10.1016/j.micpath.2004.11.001. hdl:11576/2504278. PMID 15748815.
- ↑ Makino, Kozo; Kenshiro Oshima; Ken Kurokawa; et al. (March 1, 2003). "Genome sequence of Vibrio parahaemolyticus: a pathogenic mechanism distinct from that of V. cholerae". The Lancet. 361 (9359): 743–9. doi:10.1016/S0140-6736(03)12659-1. PMID 12620739. S2CID 23443158.
- ↑ Okada, Natsumi; Tetsuya Iida; Kwon-Sam Park; et al. (Feb 2009). "Identification and Characterization of a Novel Type III Secretion System in trh-positive Vibrio parahaemolyticus Strain TH3997 Reveal Genetic Lineage and Diversityt of Pathogenic Machinery beyond the Species Level". Infection and Immunity. 77 (2): 904–913. doi:10.1128/IAI.01184-08. PMC 2632016. PMID 19075025.
- ↑ Noriea, Nicholas; CN Johnson; KJ Griffitt; DJ Grimes (September 2010). "Distribution of type III secretion systems in 'Vibrio parahaemolyticus from the northern Gulf of Mexico". Journal of Applied Microbiology. 109 (3): 953–962. doi:10.1111/j.1365-2672.2010.04722.x. PMID 20408916.
- ↑ 17.0 17.1 Letchumanan, Vengadesh; Loo, Ke-Yan; Law, Jodi Woan-Fei; Wong, Sunny Hei; Goh, Bey-Hing; Mutalib, Nurul-Syakima Ab; Lee, Learn-Han (2 July 2019). "Vibrio parahaemolyticus: The protagonist of foodborne diseases". Progress in Microbes & Molecular Biology. 2 (1). doi:10.36877/pmmb.a0000029. ISSN 2637-1049. Archived from the original on 19 June 2022. Retrieved 4 March 2025.
- ↑ Casey, Michael (4 December 2016). "New Hampshire Looks for Answers Behind Oyster Outbreaks". R&D Magazine. Associated Press. Archived from the original on 6 December 2016. Retrieved 5 December 2016.
- ↑ Penland RL, Boniuk M, Wilhelmus KR (2000). "Vibrio ocular infections on the U.S. Gulf Coast". Cornea. 19 (1): 26–9. doi:10.1097/00003226-200001000-00006. PMID 10632004. S2CID 42510694.
- ↑ "Vibrio Illnesses After Hurricane Katrina — Multiple States, August–September 2005". www.cdc.gov. Retrieved 28 February 2025.
- ↑ Morantz, Carrie A. (15 November 2005). "CDC Reports on Illnesses in Hurricane Katrina Evacuees and Relief Workers". American Family Physician. 72 (10): 2126–2134. Archived from the original on 18 July 2024. Retrieved 4 March 2025.
- ↑ Chen, Lili; Wang, Jikai; Chen, Jiang; Zhang, Ronghua; Zhang, Hexiang; Qi, Xiaojuan; He, Yue (2023). "Epidemiological characteristics of Vibrio parahaemolyticus outbreaks, Zhejiang, China, 2010-2022". Frontiers in Microbiology. 14: 1171350. doi:10.3389/fmicb.2023.1171350. ISSN 1664-302X. Archived from the original on 2025-02-03. Retrieved 2025-06-13.
{{cite journal}}: CS1 maint: unflagged free DOI (link) - ↑ Letchumanan, Vengadesh; Chan, Kok-Gan; Lee, Learn-Han (11 December 2014). "Vibrio parahaemolyticus: a review on the pathogenesis, prevalence, and advance molecular identification techniques". Frontiers in Microbiology. 5. doi:10.3389/fmicb.2014.00705. ISSN 1664-302X.
External links
Data related to Vibrio parahaemolyticus infection at Wikispecies- CDC Disease Info vibriop
- FDA Bad Bug Book entry on V. parahaemolyticus
- Type strain of Vibrio parahaemolyticus at BacDive - the Bacterial Diversity Metadatabase Archived 2023-04-27 at the Wayback Machine